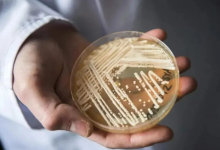
超级真菌龙头股票有哪些?超级真菌概念股票名单一览表-小李财经视角

2024年合成生物学上市公司有哪些?据小李财经视角收集汇总,中国A股市场从事合成生物学的上市公司一共有11家,其中4家在上海证券交易所上市,7家在深圳证券交易所上市。那么,合成生物学概念股有哪些?合成生物学龙头股有哪些?下面详细介绍。

合成生物学龙头股票有哪些?
合成生物学龙头股票有:科伦药业(002422)、华熙生物(688363)等。
合成生物学利好消息:
#合成生物学领域迎来新突破千亿级别黄金赛道已形成#据报道,美国南加州大学研究人员发明的一项突破性新技术,或将彻底改变合成生物学领域。该方法被称为克隆重编程和组装平铺天然基因组DNA(CReATiNG),为构建合成染色体提供了一种更简单且更具成本效益的方法。它可显著推进基因工程,并推动医学、生物技术、生物燃料生产甚至太空探索领域的进步。研究成果12月20日发表在《自然·通讯》杂志上。合成生物学,广义上是指通过构建生物功能元件、装置和系统,对细胞或生命体进行遗传学设计、改造,使其拥有满足人类需求的生物功能,甚至创造新的生物系统。合成生物学作为一项颠覆性技术和前沿技术,已成为一条新的黄金赛道,预计2025年合成生物学市场规模有望突破70亿美元。
合成生物学概念股票名单一览表:
1、科伦药业(002422),最新股价28.49元,总市值423.08亿:控股子公司川宁生物已成立“上海研究院”,依托成熟的生物发酵技术和酶技术平台,以研发创新为着力点,以合成生物学和酶工程研究为基础,向保健品原料、生物农药、高附加值天然产物、高端化妆品原料、生物可降解材料等领域发展。
2、华熙生物(688363),最新股价64.27元,总市值309.57亿:华熙生物开发的胶原蛋白水光产品处于临床前研究阶段,同时借助合成生物学技术,公司成功开发了自有知识产权的重组人源胶原蛋白原料。
3、梅花生物(600873),最新股价9.63元,总市值283.45亿:具备从菌种设计-构建-发酵-分离提取的合成生物学全链条,上半年公司搭建了合成生物学菌种改造“途径工程-元件工程-工具开发”协调发展的强劲合成生物学技术平台。
4、华恒生物(688639),最新股价116.19元,总市值183.05亿:公司是国内合成生物学龙头企业,主营产品包括氨基酸系列产品(L丙氨酸、DL-丙氨酸、β-丙氨酸、L-缬氨酸)、维生素系列产品(D-泛酸钙、D-泛醇、肌醇)等。
5、普洛药业(000739),最新股价15.15元,总市值178.55亿:普洛药业于2021年投入2000多万元建立了合成生物学实验室,在菌种基因的改造、编辑、筛选和发酵工程、酶库的建立、酶的筛选以及酶催化等方面都做了很多工作,并将新技术在部分项目中进行了运用,产品成本进一步下降,研发效率得到显著提升。
以上是“合成生物学概念股”名单一览表是根据公司市值和市场份额排序,想了解更多概念股信息请上小李财经视角。
小李财经视角